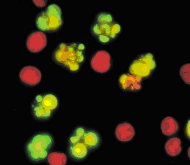
TUNEL Assay kit

Search Results
-
1 YEAR WARRANTEE
Cat. No. : 1TFS-1IS-ZGEXSCEVOSXLCORE1Y
Please Inquire for a price -
1 YEAR, PROFLEX 3X32-WELL SYSTEM BLOCK
Cat. No. : 1TFS-1IS-ZG03SCPROFLEX3X32WELL
Please Inquire for a price

![ประกาศบริษัทฯ ที่ 1/2566 ประกาศแต่งตั้งตัวแทนจำหน่ายกลุ่มผลิตภัณฑ์ Genetic Analysis Solutions จาก Thermo Fisher Scientific, Inc. [Corporate]](/userfiles/event/event_20230207_161328_000000.jpg)







